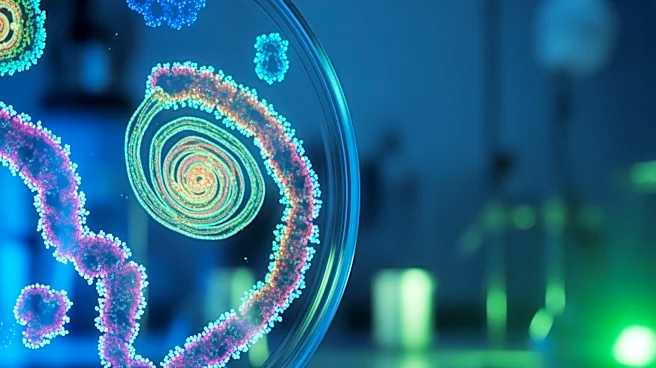
Scientists Identify Gut Biomarkers for Early Cancer Detection

What's Happening?
A recent study published in Cell Reports Medicine has revealed that vitamin D supplementation may have beneficial effects on individuals with Inflammatory Bowel Disease (IBD), which includes conditions like ulcerative colitis and Crohn's disease. The
study involved 48 adult participants with low vitamin D levels, who received weekly doses of vitamin D over 12 weeks. Results indicated that vitamin D helped 'reset' the immune system's interaction with gut bacteria, promoting immune tolerance rather than merely suppressing inflammation. Participants showed lower disease activity scores and reduced markers of inflammation, suggesting an improvement in symptoms. The study also noted changes in immunoglobulin levels, with an increase in IgA and a decrease in IgG, which are linked to more stable immune responses and reduced inflammation, respectively.
Why It's Important?
The findings of this study are significant as they suggest a potential new approach to managing IBD, a condition that affects millions of people and can lead to severe symptoms like chronic diarrhea and abdominal pain. By enhancing immune tolerance to gut bacteria, vitamin D supplementation could offer a more targeted treatment strategy, potentially reducing the need for more aggressive therapies that suppress the immune system. This could improve the quality of life for patients and reduce healthcare costs associated with managing chronic inflammation. Furthermore, the study opens avenues for further research into the role of vitamin D in other chronic inflammatory diseases, potentially broadening its therapeutic applications.
What's Next?
While the study provides promising insights, it also highlights the need for larger, long-term studies to confirm these findings and determine optimal vitamin D dosing strategies for IBD patients. Researchers are also interested in exploring the specific gut bacteria influenced by vitamin D and how these changes impact the immune landscape. Future research will aim to elucidate the biological mechanisms behind vitamin D's effects on the gut microbiome and immune system, which could lead to more personalized treatment approaches for IBD and similar conditions.